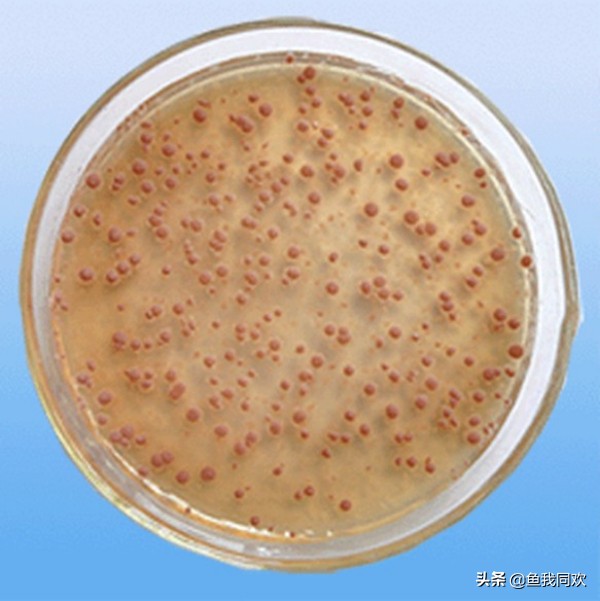
裸缸养鱼怎么培养硝化细菌,草缸不养鱼如何培养硝化细菌

怎么培养硝化细菌?相信当初刚接触水族箱的你一定有过这个疑问,其实我们平时经常说的养鱼先养水,这养水呀实际上就是在培养硝化细菌。硝化细菌并不复杂,它也是一种生命,而任何生命都有其独特的生活习性和生长条件。下面将为大家具体阐述一下,相信您在看过之后一定会有所收获,也会明白锦鲤饲养的水质保养很重要!
首先,要了解硝化细菌的作用。正如它的名字一样,硝化细菌就是一种细菌,主要是降低水体中亚硝酸盐的含量;还有一大作用是改善水质,它能分解鱼缸中食物残渣、粪便碎屑等一些清理不干净的有机物。

硝化细菌的存活条件是培养硝化细菌的重要环节。硝化细菌的存活需要水分以及很高的氧气,这些是不用担心的,因为这也是鱼类生存的必要条件。它是细菌的一种所以只能生活在生化棉、生化球、玻璃杯、陶瓷环等各种有微小细孔的滤材中。硝化细菌最适合在弱碱性的水中生活,在温度为25度左右的识货繁殖的最快。
一般在刚开始养鱼时,硝化细菌是有培养但还会有些问题,举个鱼友的例子:水总是发黄,水面还有水泡、鱼腥味、这是有什么锦鲤鱼病还是硝化细菌没有培养好?我现在有过滤棉和玻璃杯,要怎么培养硝化细菌呢?对这一问题的相应解答是:缸体的体积(容量)要和养鱼的数量还有鱼的体型成正比,不可小鱼缸养了体型较大的鱼或是鱼的数量过多,这样造成的问题是,鱼产生的**或食物残渣超过了硝化细菌的处理能力,导致硝化细菌系统失衡,这就不是没有培养好硝化细菌的问题了。

平常情况下,我们准备好足够的氧气和硝化细菌的承载体还有水,硝化细菌就会繁殖,但是有一条是很重要的,硝化细菌是吸附在含有微孔固体表面,并不能像鱼儿一样游动;假如鱼缸的水是静止不动的,那么硝化细菌可能消耗完自己周围的氧气之后就会死亡,所以为了给硝化细菌充足的氧气,必须让水体流动起来,让溶有氧气的水冲刷到硝化细菌所在的场所,为他们提供充足的氧气。要记住硝化细菌的温度在5——35度,在这指正一个误区就是,硝化细菌在冬天也是会工作的,只是降低了工作效率而已;最好是在25度左右,而这个温度恰好是大多数热带鱼的生存温度。
一些鱼友想尽快将观赏鱼请进鱼缸中,那么就说几个比较快速培养硝化细菌的方法,写的不好还望收纳。
1)添加人造硝化细菌,也就是市面上售出的有液态、粉末状、干燥孢子化等人造硝化细菌。
2)利用污染源**它的繁殖:再引入菌后,配合过滤、充气促进水流循环,在水族箱内放入新鲜的虾(去壳的),利用肉质腐烂生成的毒素作为硝化细菌的营养**硝化细菌种的繁殖。
3)将养过观赏鱼的旧水族箱中的滤材或滤砂移入新的水族箱引入菌种,因为以前饲养过观赏鱼用过的滤材上附有大量的硝化细菌。
4)家庭饲养观赏鱼培养硝化细菌:在新缸中放几只死虾或是其它锦鲤食物的活饵(除虾仁外,因为虾仁自己就会被硝化细菌分解掉),过几天再捞出来,这样使水质受到污染,水中就有充足的硝化细菌的食物,能够使硝化细菌快速的繁殖。
关注更多水族文章,视频分享。